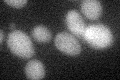
YJR058C
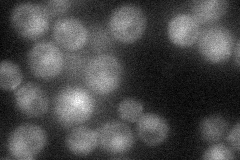
YJR058C
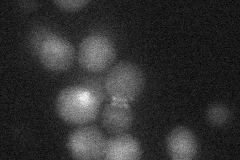
YJR058C
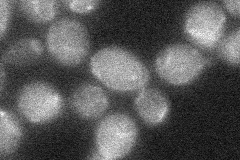
YJR058C
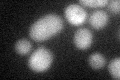
YJR058C

View description
Small subunit of the clathrin-associated adaptor complex AP-2, which is involved in protein sorting at the plasma membrane; related to the sigma subunit of the mammalian plasma membrane clathrin-associated protein (AP-2) complex
Localization:
Intensity:
Fold change:
Significance:
-
C’ GFP library in SD
below threshold17.32 -
N' NOP1pr-GFP in SD
punctate,bud neck,nucleus40.4728 -
N' TEF2pr-mCherry in SD
punctate,bud neck,nucleus17.0491 -
N' NATIVEpr-GFP in SD

missing0 -
N' TEF2pr-VC and Cyto-VN in SD
below threshold24.0536 -
C’ GFP library in SD+DTT
cytosol17.871.03No -
C’ GFP library in SD+H2O2

cytosol18.11.04No -
C’ GFP library in Starvation Media

cytosol16.850.97No -
C’ GFP library on the background of Pup2-DaMP

below threshold -
C’ GFP library on the background of CCT mutant

below threshold15.59390.90006No
